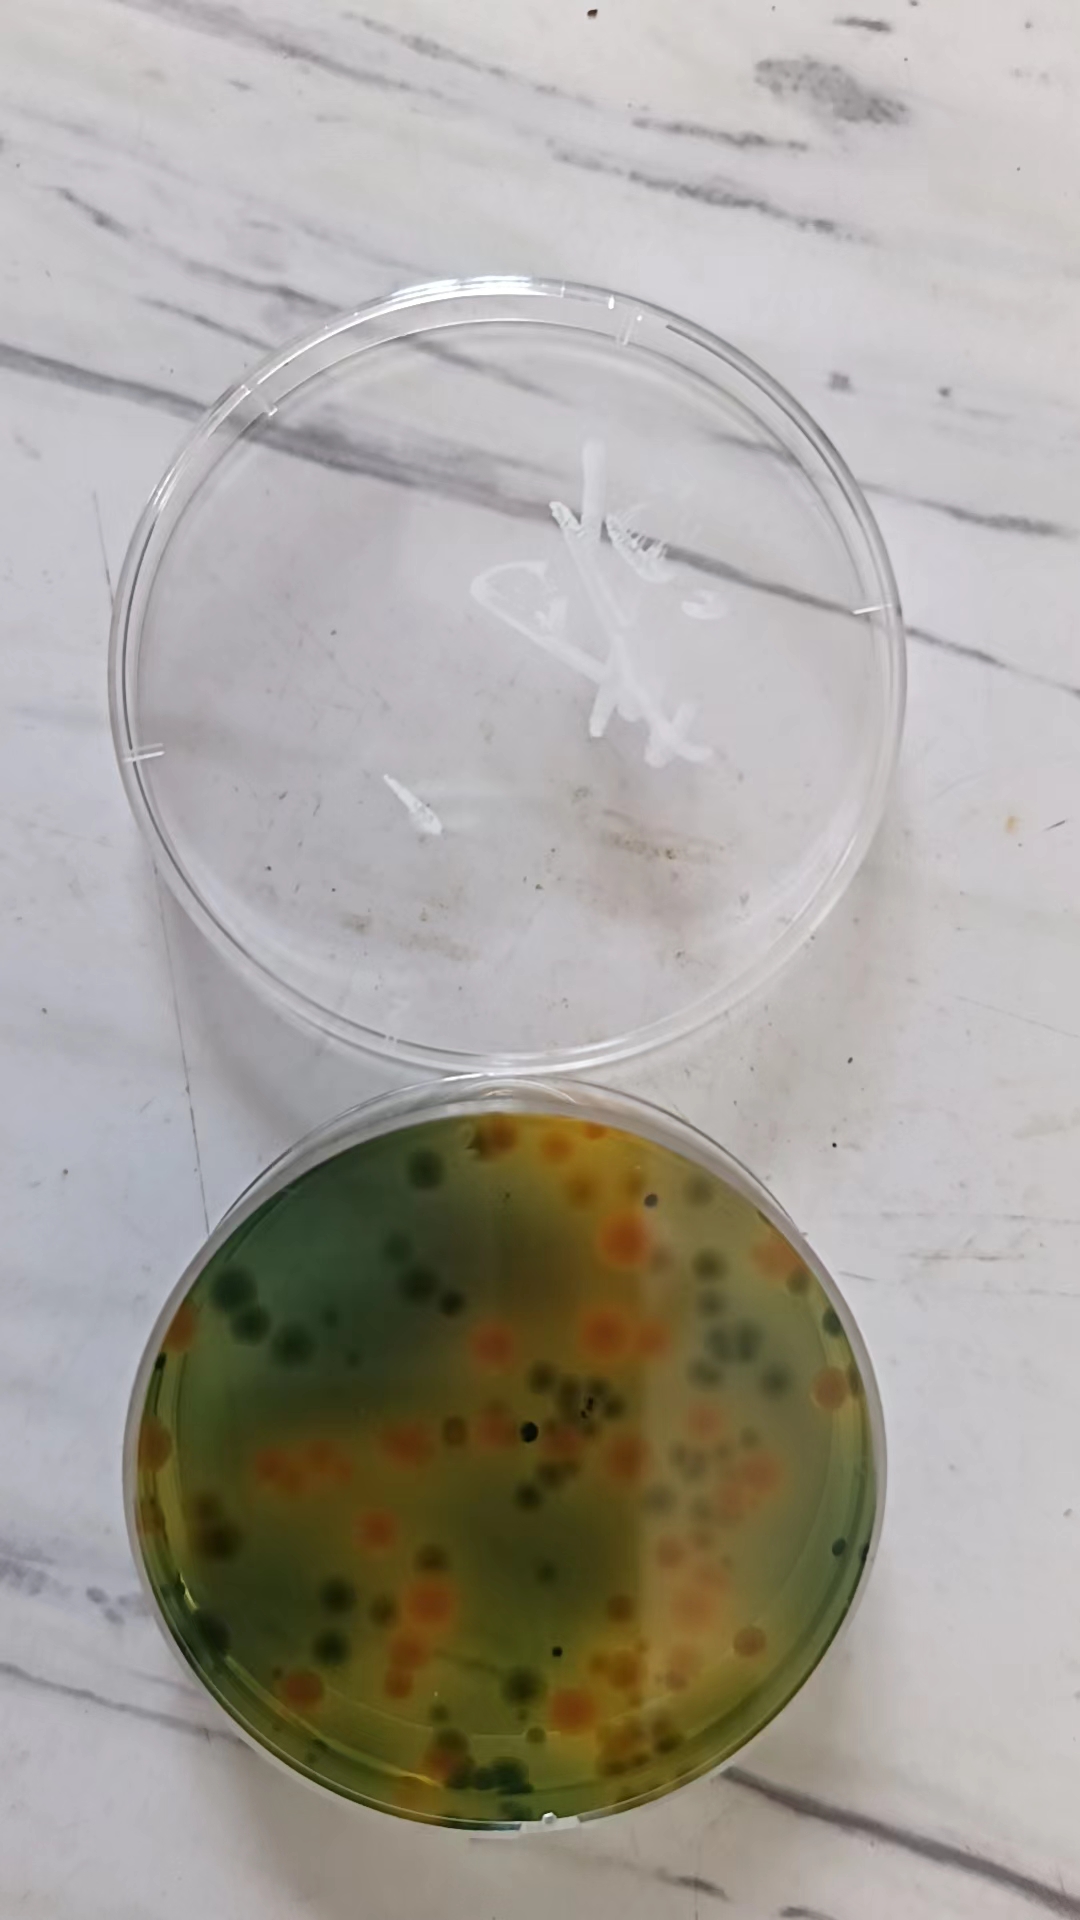
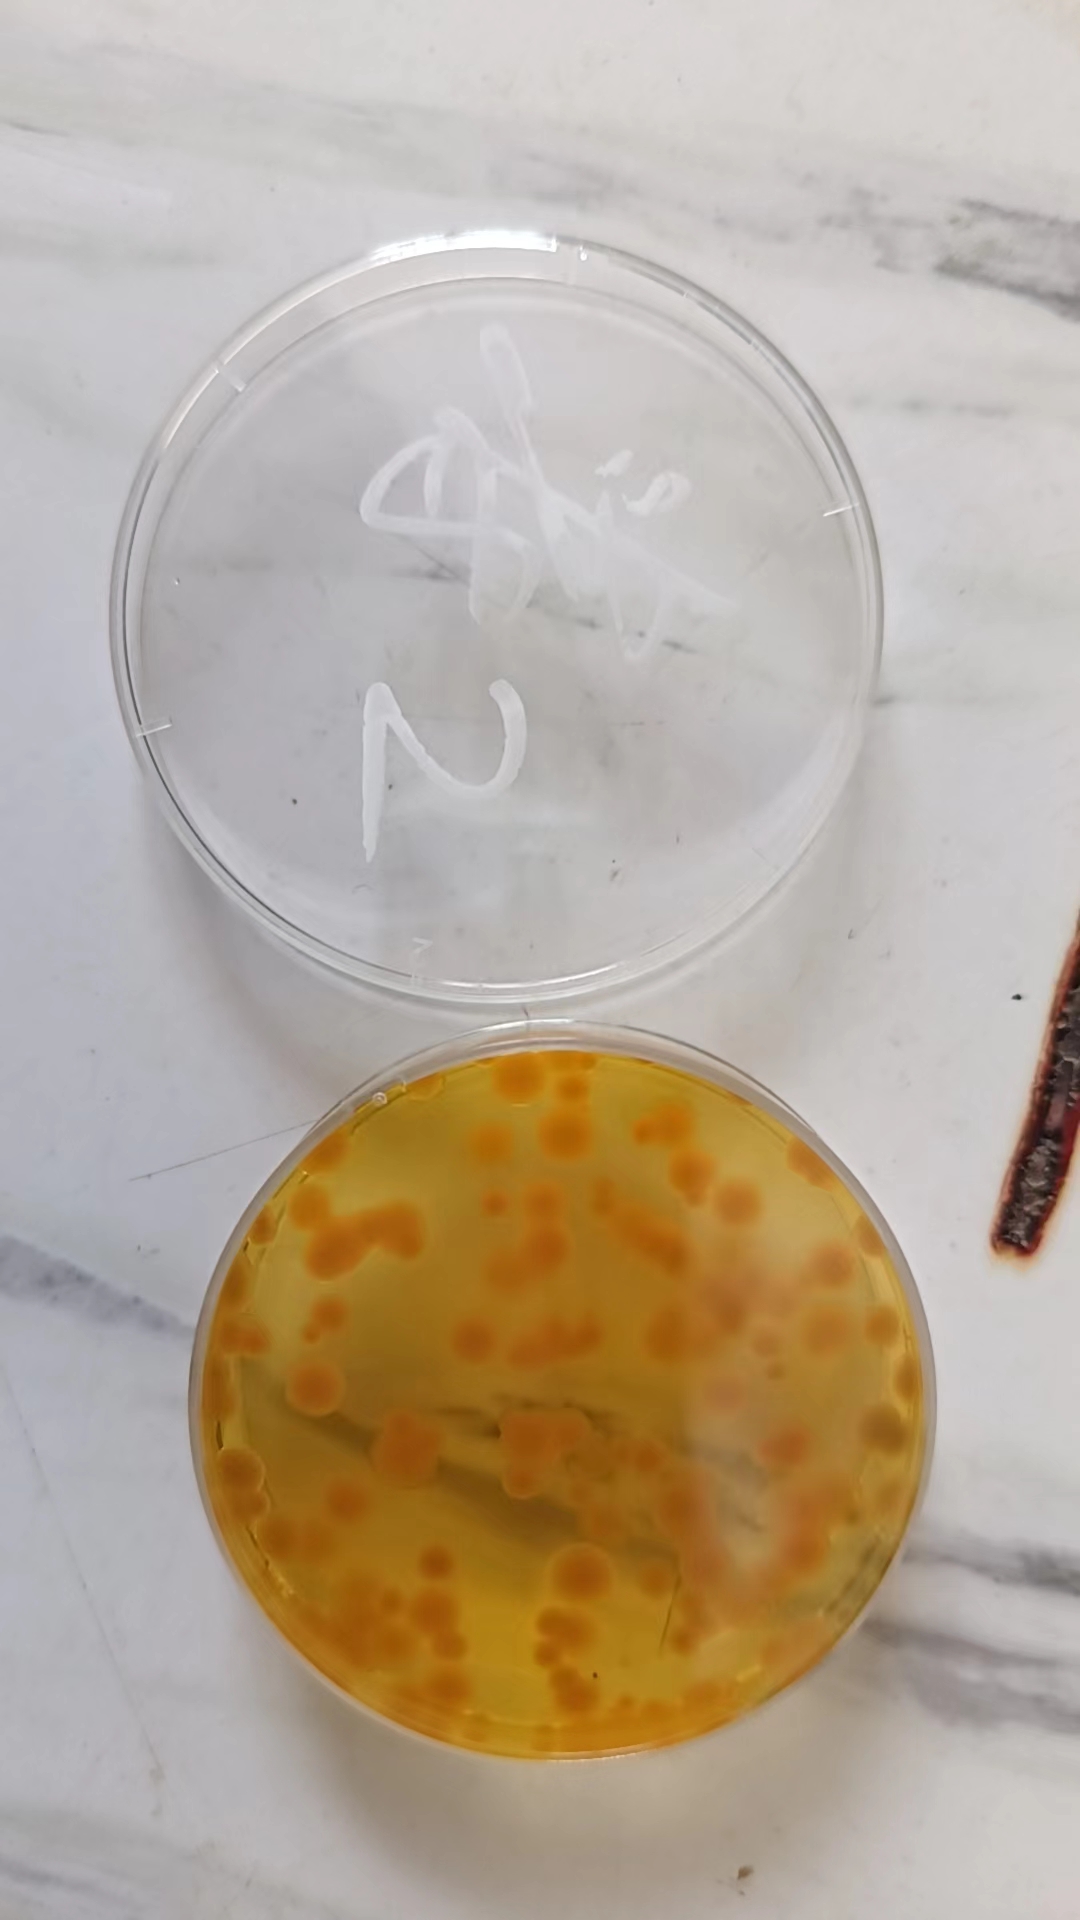
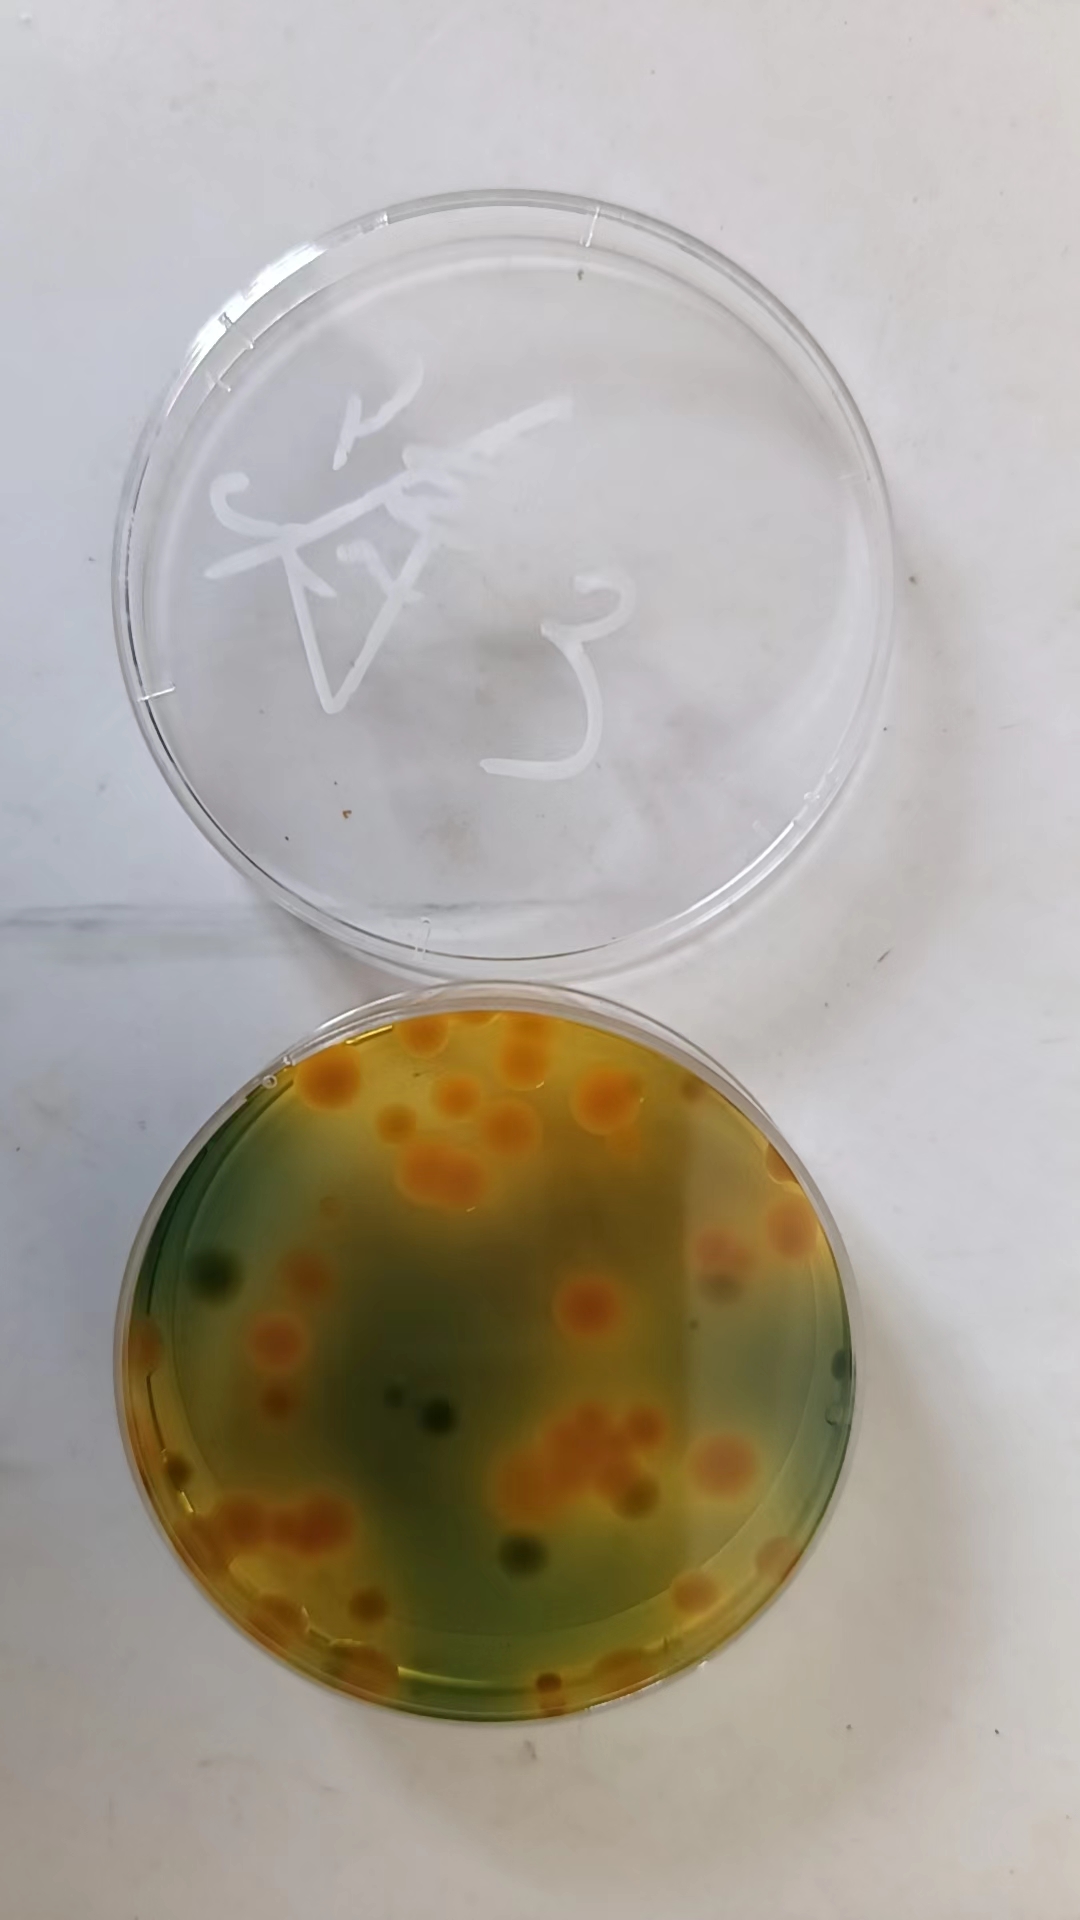

随着气温逐渐升高,弧菌病进入了易发生阶段,应当及时的预防弧菌爆发,尤其是雨天之前的预防。弧菌作为条件性致病菌,发病前兆以及时间无法掌握,所以应当以预防为主。

方案一 弧立净

本品为蛭弧菌冻干粉,对于弧菌的防控和治理效果表现良好,从生物竞争的层面去处理弧菌,温和有效。预防阶段,一瓶用两亩地,在弧菌发病阶段一瓶用一亩地。
方案二 过硫酸氢钾复合盐泡腾片+中仁金碘


预防阶段的话,采用50%过硫即过硫酸氢钾复合盐泡腾片与中仁金碘搭配使用,两袋过硫与一瓶中仁金碘可以使用到6-10亩地,视水深而定。
50%的过硫和碘溶液作为消毒灭菌的药品,对于弧菌防控效果很好,其中碘溶液要避光使用,而50%的过硫应控制用量,不应过量使用,以防过量使用导致瘦水缺氧。并且碘溶液化水泼洒,与50%过硫泡腾片搭配使用,可以达到一个水体消毒和底层消毒的立体消毒效果,从而更好的预防弧菌。
本文供稿:侯泽龙,杨光
编辑审核:张传宝,臧学运